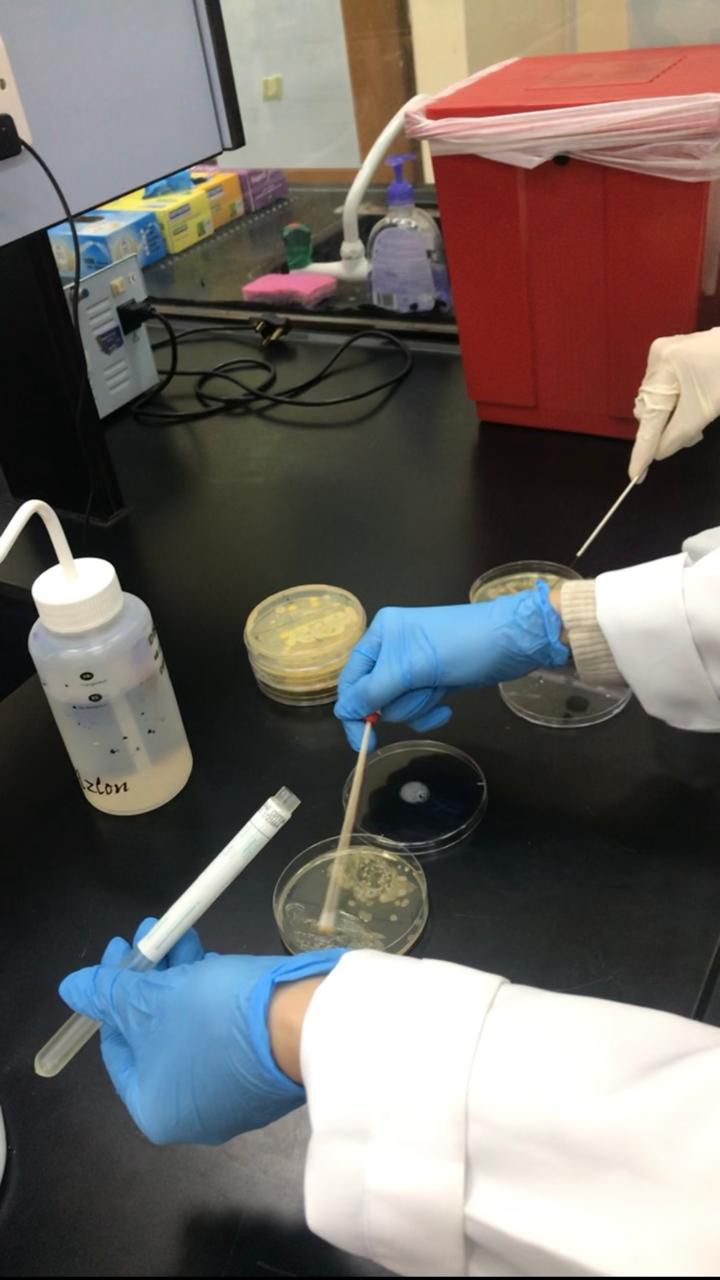

Finally, a Routine That Solves Acne for Real
Our pharmacist developed system fights acne from all angles AND guides your habits for lasting results because real clear skin isn’t magic, it’s a routine
Discover the Routine

Made of natural ingredients

Tested formula

cruelty free

ingredients sourced from Morocco & Spain
Sulfate-Free Foaming face wash
Anti- Imperfection serum
Hydrating & Repairing serum
Acne causing habit checklist
Step 1 – Sulfate-Free Foaming Face Wash: A gentle yet effective cleanser that purifies without stripping. It removes dirt, oil, and impurities while respecting your skin’s natural barrier. Leaving it clean, fresh, and calm.
Step 2 – Anti-Imperfection Serum: A powerful formula that targets active breakouts and unclogs pores. It works deep within your skin to reduce inflammation and prevent future breakouts, promoting a smoother, clearer complexion.
Step 3 – Hydrating & Repairing Serum: Your skin’s daily dose of comfort. It replenishes lost moisture, strengthens the skin barrier, and controls excess oil. When paired with the Anti-Imperfection Serum, it enhances its results while keeping your skin calm, nourished, and glowing.
Sulfate-free foaming face wash:
Aqua, Disodium EDTA, Citric Acid, Sodium C14-16 Olefin Sulfonate, Cocamidopropyl Betaine, Disodium Laureth Sulfosuccinate, Argania Spinosa Kernel Oil, Phenoxyethanol, Ethylhexylglycerin, Polyquaternium-7.
Anti-imperfection serum:
Aqua, Propanediol, Propylene Glycol, Glycerin, Aloe Barbadensis Extract, Salicylic Acid, Ammonium Polyacryloyldimethyl Taurate, Allantoin, Ethylhexylglycerin, Phenoxyethanol, Disodium EDTA, Sodium Hydroxide.
Hydrating and Repairing serum:
Aqua, Aloe Barbadensis Leaf Extract, Urea, Glycerin, Rosa Damascena Flower Water, Niacinamide, Panthenol, Cucumis Sativus Fruit Extract, Ammonium Polyacryloyldimethyl Taurate, Sodium Hyaluronate, Glycyrrhiza Glabra Root Extract, Curcuma Longa Root Extract, Camellia Sinensis Leaf Extract, Calendula Officinalis Flower Extract, Chamomilla Recutita Flower Extract, Allantoin, Ethylhexylglycerin, Disodium EDTA, Phenoxyethanol.
Step 1: Sulfate-free foaming face wash
Apply it daily, Massage in to wet skin in circular motions then rinse thoroughly.
Step 2: Anti-Imperfections serum
Apply into dry skin, start Appling it 3 times per week, increase to 4-5 times as your skin needs, wait 3 minuets and move to next step.
Step 3: Hydrating & Repairing serum
Apply it daily, use 2-3 pumps and massage onto your face.
What our customers say
(4.7 / 5)

Made of natural ingredients

Tested formula

cruelty free

ingredients sourced from Morocco & Spain
Our products


“I know how much acne can affect your confidence, and I want you to know you’re not alone. Every product we create is designed to help your skin heal, your confidence grow, and for you to feel radiant in your own skin.”
ABOUT glosan
A word from the founder

Next day delivery
Cash on delivery
Free shipping
Our skincare products are produced under GMP-certified standards and registered with Dubai Municipality ensuring quality, safety, and compliance at every step.

Manufactured with Care, Certified for Safety.


Meet our acne-fighting trio
clear skin start here
sulfate-free foaming face wash
Anti-Imperfection
serum
Hydrating and Repair
serum
STEP 1
STEP 2
STEP 3


SEE WHAT IS INSIDE
SEE WHAT IS INSIDE
SEE WHAT IS INSIDE
glosan vs. The Rest
This isn’t just another acne product , we’re the smarter, gentler and we’re the trio that actually cleans ,treats, and repairs.

Other brands
Natural ingredients
FULL ROUTINE THAT TARGET ACNE
24/7 SUPPORT FOR YOU SKIN BY PHARMACIST
GENTIL FOrmula
RegistereD PRODUCT
NO HARSH CHEMICALS
CRUelTY FREE
FAQ
Have another question?
CONTACT US
we are based in UAE.
We source our ingredients from Morocco & Spain.
Our formulas are developed by a pharmacist ,under the supervision of a cosmetic doctor with long experience in cosmetic formulations . Each product is designed with both scientific precision and a passion for skincare to ensure safety, effectiveness, and real results.
Our products are specially designed for anyone struggling with acne, whiteheads, or blackheads. Whether you’re dealing with occasional breakouts or persistent acne-prone skin, our formulas help clear clogged pores, reduce inflammation, and control oil production, leaving your skin smoother, calmer, and healthier.
Everyone’s skin is unique, so results can vary from person to person. In many cases, you may experience a purging phase during the first few weeks this happens when active ingredients begin to unclog pores and bring impurities to the surface. While it can look like your skin is getting worse, it’s actually a sign that the formula is working deeply.You may start noticing visible improvements in as little as 14 days, but for best and final results, we recommend giving your skin 8 to 12 weeks to complete the full renewal cycle.
Yes! Even if you don’t have acne, you can enjoy our products. if you are looking for gentile cleanser Our sulfate-free face wash deeply cleanse while still being gentile, and if your are looking for rich hydrating serum you can try our Hydrating & Repairing serum that provides deep moisture and supports overall skin health.
Yes our products are approved and registered by the ministry of health in Dubai.
Currently we offer delivery to UAE and GCC.
UAE delivery takes between 1-3 days and for the rest of GCC it take 3-5 days .
Next day delivery
Cash on delivery
Free shipping